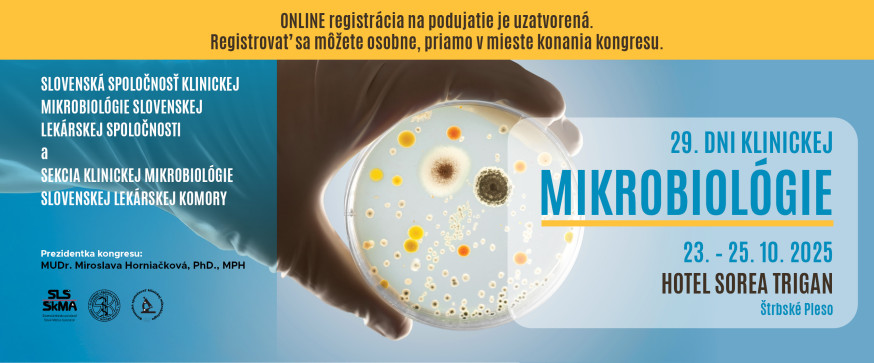
web | 29. Dni klinickej mikrobiológie

Prezidentka kongresu:
MUDr. Miroslava Horniačková, PhD., MPH
Organizačný a vedecký výbor:
MUDr. Miroslava Horniačková, PhD., MPH
MUDr. Zuzana Kónyová, PhD.
MUDr. Zuzana Bečková, PhD.
RNDr. Vojtech Boldiš, PhD.
doc. MUDr. Adriána Liptáková, PhD., mim. prof.
MUDr. Monika Czirfuszová, PhD.
doc. RNDr. Lívia Slobodníková, PhD.
MUDr. Rudolf Botek
doc. MUDr. Milan Nikš, CSc.
prof. RNDr. František Ondriska, CSc.
MUDr. Emília Miková
Mgr. Alena Ofukaná
Usporiadatelia:
Slovenská spoločnosť klinickej mikrobiológie SLS
Sekcia klinickej mikrobiológie SLK
Odborné témy:
- Antimikrobiálne stewardship, sledovanie spotreby antimikrobiálnych látok
- Antimikrobiálna rezistencia
- Perspektívy antimikrobiálnej terapie
- Nové infekčné ochorenia, nové alebo novo sa objavujúce patogény
- Endokarditídy
- Ochorenia spôsobené mikroskopickými hubami, rezistencia na antifungálne látky
- Ochorenia a nové možnosti diagnostiky vírusových infekcií
- Sekcia určená zdravotníckym laborantom
- Varia